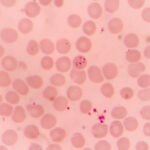

Beschreibung
Buschgelbfieber, auch bekannt als Dschungelgelbfieber oder sylvatisches Gelbfieber, ist eine Unterart des Gelbfiebers, die durch das Gelbfiebervirus verursacht wird. Zu den Symptomen gehören Fieber, Kopfschmerzen, Muskelschmerzen, Übelkeit, Erbrechen und Gelbsucht. Schwere Fälle können zu Multiorganversagen und zum Tod führen.
Buschgelbfieber tritt vor allem in sylvatischen (Wald-)Gebieten auf, wo wilde Primaten als Reservoir für das Virus dienen. Die Krankheit wird durch Mückenstiche auf den Menschen übertragen, wobei das Virus in Zyklen zwischen Stechmücken und Primaten zirkuliert.
Die Prävalenz des Buschgelbfiebers variiert je nach geografischer Lage und der Dichte der Primaten- und Mückenpopulationen. In der Vergangenheit traten Ausbrüche in tropischen Regionen Afrikas und Südamerikas auf, insbesondere in bewaldeten Gebieten.
Zu den Komplikationen des Buschgelbfiebers können Leberschäden, Nierenversagen, Atemnot und neurologische Symptome wie Verwirrung und Krampfanfälle gehören. Schwere Fälle können zu hämorrhagischem Fieber und zum Tod führen.
Die Diagnose von Buschgelbfieber umfasst in der Regel eine klinische Bewertung der Symptome, unterstützt durch Labortests zur Bestätigung des Gelbfiebervirus. Die Behandlung konzentriert sich auf unterstützende Maßnahmen, um die Symptome zu lindern und Komplikationen zu verhindern.
Die unmittelbare Ursache des Buschgelbfiebers ist das Gelbfiebervirus, das vor allem durch infizierte Stechmücken übertragen wird. Zu den Risikofaktoren für eine Ansteckung gehört der Aufenthalt oder die Reise in Regionen, in denen das Virus endemisch ist, insbesondere in bewaldeten Gebieten mit hoher Mückenaktivität.
Zur Vorbeugung von Buschgelbfieber gehört in erster Linie die Impfung mit dem Gelbfieberimpfstoff, der eine lang anhaltende Immunität gegen das Virus verleiht. Darüber hinaus können die Kontrolle der Mückenpopulationen sowie die Verwendung von Insektenschutzmitteln und Schutzkleidung dazu beitragen, das Infektionsrisiko zu verringern.
Die Biologie dahinter
Busch-Gelbfieber befällt in erster Linie die Leber, ein lebenswichtiges Organ, das für die Entgiftung, den Stoffwechsel und die Produktion lebenswichtiger Proteine zuständig ist. Unter normalen Bedingungen filtert die Leber Giftstoffe aus dem Blut, verarbeitet Nährstoffe und stellt Proteine her, die für die Blutgerinnung und die Immunfunktion erforderlich sind. Bei einer Infektion mit dem Gelbfiebervirus wird die Leber jedoch zum Ziel der Virusreplikation, was zu Entzündungen und Gewebeschäden führt.
Das Virus infiziert die Leberzellen, stört ihre normale Funktion und verursacht die Freisetzung von Entzündungsmolekülen, den so genannten Zytokinen. Diese Entzündungsreaktion führt zu einer Leberschädigung, die durch Hepatozytennekrose und eingeschränkte Leberfunktion gekennzeichnet ist. Mit dem Fortschreiten der Infektion wird die Fähigkeit der Leber, ihre wesentlichen Stoffwechsel- und Entgiftungsfunktionen zu erfüllen, beeinträchtigt, was zu Gelbsucht, Koagulopathie und anderen systemischen Manifestationen einer Leberfunktionsstörung führt. Schwere Fälle von Buschgelbfieber können zu akutem Leberversagen, Multiorganversagen und Tod führen.
Arten und Symptome
In diesem Abschnitt werden wir die Arten und Symptome des Buschgelbfiebers untersuchen. Buschgelbfieber äußert sich durch unterschiedliche Symptome, die sich im Verlauf der Krankheit entwickeln.
Symptome:
Buschgelbfieber äußert sich durch eine Reihe von Symptomen, die sich im Verlauf der Krankheit entwickeln:
Anfangsphase: Bei den Patienten können plötzlich auftretende Symptome wie Fieber, Kopf- und Muskelschmerzen, Übelkeit und Erbrechen auftreten, die an eine gewöhnliche grippeähnliche Erkrankung erinnern.
Fortschreiten: Mit dem Fortschreiten der Krankheit können schwerwiegendere Symptome auftreten, darunter Gelbsucht (Gelbfärbung von Haut und Augen), dunkler Urin, Bauchschmerzen und Leberfunktionsstörungen.
Schwere Erscheinungsformen: In schweren Fällen können die Patienten hämorrhagische Symptome entwickeln, wie z. B. Blutungen aus dem Zahnfleisch, der Nase oder dem Magen-Darm-Trakt. In einigen Fällen können auch neurologische Symptome wie Verwirrung und Krampfanfälle auftreten.
Komplikationen
Die Komplikationen des Buschgelbfiebers können schwerwiegend und lebensbedrohlich sein. Sie umfassen:
Leberversagen: Das Virus kann erhebliche Leberschäden verursachen, die zu Leberversagen und Leberfunktionsstörungen führen.
Hämorrhagie: In schweren Fällen kann es zu hämorrhagischen Erscheinungen kommen, wie z. B. Blutungen aus dem Zahnfleisch, der Nase oder dem Magen-Darm-Trakt.
Nierenfunktionsstörung: Buschgelbfieber kann zu Nierenfunktionsstörungen führen, die die Fähigkeit des Körpers, Abfallstoffe zu filtern und Elektrolyte zu regulieren, beeinträchtigen.
Neurologische Komplikationen: In einigen Fällen kann es bei Patienten zu neurologischen Komplikationen wie Enzephalitis oder Meningitis kommen, die zu Verwirrung, Krampfanfällen und verändertem Geisteszustand führen.
Multi-Organversagen: In schweren Fällen kann die Krankheit rasch fortschreiten und zu Multiorganversagen und Tod führen, wenn sie nicht umgehend behandelt wird.
Die frühzeitige Erkennung der Symptome und ein schnelles medizinisches Eingreifen sind entscheidend für die Verbesserung der Ergebnisse und die Verringerung des Risikos von Komplikationen.
Untersuchung und Diagnose
Die Diagnose von Buschgelbfieber umfasst eine Kombination aus klinischer Untersuchung, Labortests und bildgebenden Untersuchungen, um das Vorhandensein des Virus zu bestätigen und den Schweregrad der Krankheit zu bestimmen.
Klinische Untersuchung:
Eine umfassende klinische Untersuchung ist für die Diagnose von Buschgelbfieber unerlässlich. Sie beginnt mit einer gründlichen Anamnese, um eine mögliche Exposition gegenüber dem Virus festzustellen und das Auftreten und den Verlauf der Symptome zu ermitteln. Der Arzt erkundigt sich nach kürzlichen Reisen in endemische Gebiete, in denen die Krankheit weit verbreitet ist. Es folgt eine körperliche Untersuchung, bei der vor allem die Vitalzeichen überprüft und auf Anzeichen von Gelbsucht, Druckempfindlichkeit des Bauches und neurologische Defizite geachtet wird. Das Vorhandensein von Symptomen wie Fieber, Kopfschmerzen, Muskelschmerzen und Erbrechen kann den Verdacht auf Buschgelbfieber wecken.
Labortests und Bildgebung:
Labortests spielen eine entscheidende Rolle bei der Bestätigung der Diagnose von Buschgelbfieber und der Beurteilung des Schweregrads der Erkrankung. Zu den relevanten Tests gehören:
Serologische Tests: Mit dem Enzymimmunoassay (ELISA) und der Polymerase-Kettenreaktion (PCR) lassen sich spezifische Antikörper oder virale RNA in Blutproben nachweisen, die das Vorhandensein des Virus bestätigen.
Leberfunktionstests: Bluttests wie Alanin-Aminotransferase (ALT), Aspartat-Aminotransferase (AST) und Bilirubinspiegel helfen, die Leberfunktion zu beurteilen und das Ausmaß der Leberschädigung zu ermitteln.
Vollständiges Blutbild (CBC): Das Blutbild kann eine Leukopenie (niedrige Anzahl weißer Blutkörperchen), Thrombozytopenie (niedrige Anzahl von Blutplättchen) und Anämie aufzeigen, die bei Patienten mit Buschgelbfieber häufig vorkommen.
Bildgebende Untersuchungen: Bildgebende Untersuchungen wie Ultraschall oder Computertomografie (CT) können durchgeführt werden, um das Ausmaß der Organschädigung, insbesondere der Leber- und Nierenbeteiligung, zu beurteilen.
Virusisolierung: In einigen Fällen kann zur endgültigen Diagnose eine Virusisolierung aus Blut oder anderen Körperflüssigkeiten in spezialisierten Labors versucht werden.
Eine schnelle und genaue Diagnose des Buschgelbfiebers ist entscheidend für die Einleitung einer angemessenen medizinischen Behandlung und die Vermeidung von Komplikationen. Eine engmaschige Überwachung der Laborparameter und des klinischen Zustands ist für die Beurteilung des Krankheitsverlaufs und für Behandlungsentscheidungen unerlässlich.
Therapie und Behandlungen
Die Behandlung des Buschgelbfiebers konzentriert sich auf die unterstützende Pflege, um die Symptome zu lindern, Komplikationen zu beherrschen und weitere Organschäden zu verhindern. Eine frühzeitige Diagnose und ein rasches medizinisches Eingreifen sind entscheidend für die Verbesserung der Ergebnisse bei den betroffenen Personen.
Unterstützende Behandlung:
Flüssigkeitsmanagement: Intravenöse Flüssigkeitszufuhr zur Aufrechterhaltung der Hydratation und des Elektrolytgleichgewichts, insbesondere bei Patienten mit Dehydratation aufgrund von Erbrechen und Fieber.
Fieberkontrolle: Fiebersenkende Medikamente wie Paracetamol können eingesetzt werden, um das Fieber zu senken und die Beschwerden zu lindern.
Schmerzbehandlung: Analgetika wie Ibuprofen oder Paracetamol werden verschrieben, um Muskel- und Kopfschmerzen zu lindern, die häufige Symptome von Buschgelbfieber sind.
Behandlung von Komplikationen:
Kontrolle von Blutungen: In schweren Fällen mit hämorrhagischen Manifestationen können Bluttransfusionen erforderlich sein, um verlorenes Blutvolumen zu ersetzen und die Gerinnungsfunktion zu verbessern.
Unterstützung der Leber: Bei Patienten mit Leberfunktionsstörungen können unterstützende Maßnahmen wie hepatoprotektive Medikamente und eine genaue Überwachung der Leberfunktionstests erforderlich sein.
Prävention von Sekundärinfektionen: Prophylaktische Antibiotika können verschrieben werden, um bakterielle Infektionen zu verhindern, insbesondere bei Patienten mit geschwächtem Immunsystem.
Intensivmedizinische Unterstützung:
Beatmungsunterstützung: Bei Atemversagen oder akutem Atemnotsyndrom (ARDS) kann eine mechanische Beatmung zur Unterstützung der Atmung erforderlich sein.
Nierenersatztherapie: Patienten mit Nierenversagen benötigen möglicherweise eine Nierenersatztherapie wie Hämodialyse oder kontinuierliche Nierenersatztherapie (CRRT), um das Flüssigkeits- und Elektrolytgleichgewicht aufrechtzuerhalten.
Unterstützung bei der Ernährung: Patienten, die aufgrund einer schweren Erkrankung oder gastrointestinaler Symptome keine orale Aufnahme vertragen, können enterale oder parenterale Ernährung erhalten.
Überwachung und Beobachtung:
Eine engmaschige Überwachung der Vitalparameter, des Flüssigkeitshaushalts, der Laborparameter und des klinischen Zustands ist für die Beurteilung des Krankheitsverlaufs und für Therapieentscheidungen unerlässlich. Regelmäßige Untersuchungen auf Komplikationen wie Blutungen, Organversagen und Sekundärinfektionen sind entscheidend für rechtzeitiges Eingreifen und optimale Ergebnisse. Die Zusammenarbeit mit multidisziplinären Teams, darunter Spezialisten für Infektionskrankheiten, Intensivmediziner und Betreuer, ist für eine umfassende Behandlung des Buschgelbfiebers unerlässlich.
Ursachen und Risikofaktoren
In diesem Abschnitt werden die direkten Ursachen von Gelbfieber untersucht und die wichtigsten Risikofaktoren genannt, die die Anfälligkeit einer Person für die Krankheit erhöhen.
Auslöser:
Gelbfieber wird durch das Gelbfiebervirus (YFV) verursacht, ein Mitglied der Familie der Flaviviridae. Das Virus wird in erster Linie durch den Stich infizierter Stechmücken, insbesondere Aedes- oder Haemagogus-Arten, auf den Menschen übertragen. Nachdem das Virus durch den Speichel der Mücke in den Blutkreislauf gelangt ist, greift es verschiedene Organe an, mit einer besonderen Affinität zur Leber. Hier kommt es zu einer raschen Virusvermehrung, die zu einer Schädigung der Hepatozyten führt und eine Entzündungsreaktion auslöst. Im weiteren Verlauf der Infektion kann sich das Virus auf andere Organe ausbreiten, was zu den für Gelbfieber charakteristischen systemischen Erscheinungen führt.
Risikofaktoren:
Mehrere Faktoren erhöhen das individuelle Risiko einer Gelbfieberinfektion und der damit verbundenen Komplikationen:
Geografischer Standort: Der Aufenthalt in oder die Reise in Regionen, in denen Gelbfieber endemisch ist oder in denen es zu Ausbrüchen kommt, erhöht die Wahrscheinlichkeit einer Infektion mit dem Virus.
Exposition gegenüber Mücken: Der Aufenthalt im Freien, insbesondere während der Hauptaktivitätszeit der Mücken, erhöht das Risiko von Mückenstichen und der anschließenden Übertragung des Gelbfiebervirus.
Impfstatus: Wer nicht gegen Gelbfieber geimpft ist, hat ein höheres Infektionsrisiko, insbesondere in Gebieten, in denen die Übertragung noch andauert.
Berufliche Exposition: Bestimmte Berufe wie Forstarbeiter, Plantagenarbeiter und Personen, die sich in bewaldeten Gebieten im Freien aufhalten, haben ein höheres Risiko, mit Mücken in Kontakt zu kommen und Gelbfieber zu übertragen.
Immunstatus: Personen mit geschwächtem Immunsystem, einschließlich HIV/AIDS-Patienten oder Personen, die sich einer immunsuppressiven Therapie unterziehen, können anfälliger für schwere Gelbfieberinfektionen und Komplikationen sein.
Obwohl bestimmte Faktoren das Risiko einer Gelbfieberübertragung erhöhen können, ist das Vorhandensein dieser Risikofaktoren keine Garantie für eine Infektion. Außerdem entwickeln nicht alle Personen, die dem Virus ausgesetzt sind, symptomatisches Gelbfieber. Die Impfung ist nach wie vor die wirksamste Präventionsmethode für Personen, die sich in endemischen Gebieten aufhalten oder dorthin reisen.
Krankheitsverlauf und Prognose
Dieser Abschnitt soll einen Einblick in den Verlauf des Buschgelbfiebers geben, einschließlich seiner Stadien und des allgemeinen Zeitrahmens, gefolgt von einem umfassenden Überblick über die damit verbundene Prognose.
Krankheitsverlauf:
Das Buschgelbfieber verläuft in der Regel in verschiedenen Stadien:
Inkubationszeit: Nach der Übertragung des Gelbfiebervirus durch Mückenstiche folgt eine Inkubationszeit von 3 bis 6 Tagen, in der die Betroffenen symptomlos bleiben.
Akute Phase: Gekennzeichnet durch ein plötzliches Auftreten von Symptomen wie Fieber, Kopf- und Muskelschmerzen, Übelkeit, Erbrechen und Müdigkeit. Diese Phase dauert etwa 3 bis 4 Tage und kann in schweren Fällen mit Gelbsucht einhergehen.
Toxische Phase: Bei etwa 15 % der Betroffenen tritt die toxische Phase ein, die durch eine Verschlimmerung der Symptome wie hohes Fieber, Gelbsucht, Bauchschmerzen und hämorrhagische Erscheinungen gekennzeichnet ist. Schwere Fälle können zu Multiorganversagen und Tod führen.
Prognose:
Die Prognose des Buschgelbfiebers hängt von Faktoren wie Alter, Immunstatus und Schweregrad der Erkrankung ab. Leichte Fälle klingen in der Regel innerhalb von 1 bis 2 Wochen mit unterstützender Behandlung ab, während schwere Fälle schnell fortschreiten können, was zu lebensbedrohlichen Komplikationen und einer hohen Sterblichkeitsrate führt. Eine frühzeitige Erkennung und ein aggressives Management sind entscheidend für die Verbesserung der Behandlungsergebnisse, was die Bedeutung eines raschen medizinischen Eingreifens und des Zugangs zu unterstützenden Therapien unterstreicht.
Prävention
Die Vorbeugung von Buschgelbfieber ist von größter Bedeutung, um die Ausbreitung der Krankheit einzudämmen und die Menschen vor den potenziell schweren Folgen zu schützen. Um das Risiko einer Ansteckung und Übertragung des Gelbfiebervirus zu minimieren, werden verschiedene Präventionsmaßnahmen eingesetzt. Dieser Abschnitt gibt einen umfassenden Einblick in die verfügbaren Präventionsstrategien für Buschgelbfieber.
Impfung:
Die wirksamste Vorbeugungsmaßnahme gegen Gelbfieber ist die Impfung. Der Gelbfieberimpfstoff ist hochwirksam und verleiht eine lang anhaltende Immunität. Die Impfung wird Personen empfohlen, die in Gebieten leben oder dorthin reisen, in denen Gelbfieber endemisch ist oder in denen es zu Ausbrüchen gekommen ist.
Mückenkontrolle:
Da Buschgelbfieber in erster Linie durch den Stich infizierter Mücken übertragen wird, sind Maßnahmen zur Mückenbekämpfung unerlässlich. Dazu gehören die Beseitigung von Brutstätten durch die Entfernung von stehendem Wasser, die Verwendung von Insektiziden zur Abtötung erwachsener Mücken und die Anwendung von Schutzmaßnahmen wie Moskitonetzen und Repellentien.
Reisevorkehrungen:
Reisende, die Regionen besuchen, in denen das Buschgelbfieber endemisch ist, sollten Vorkehrungen treffen, um Mückenstiche zu vermeiden. Dazu gehören das Tragen langärmeliger Kleidung, die Verwendung von DEET- oder Picaridin-haltigen Insektenschutzmitteln und der Aufenthalt in geschlossenen Räumen während der Hauptaktivitätszeiten der Mücken.
Interventionen im Bereich der öffentlichen Gesundheit:
Die Gesundheitsbehörden spielen eine entscheidende Rolle bei der Prävention von Buschgelbfieber durch Überwachung, Früherkennung von Fällen und Durchführung von Impfkampagnen in Hochrisikogebieten. Darüber hinaus sensibilisieren Gesundheitserziehungs- und Aufklärungsprogramme das Bewusstsein für die Krankheit und fördern präventive Verhaltensweisen.
Grenzkontrollmaßnahmen:
Einige Länder verlangen von Reisenden, die aus Regionen einreisen, in denen die Krankheit endemisch ist, den Nachweis einer Gelbfieberimpfung. Dies trägt dazu bei, die Einschleppung des Virus in nicht endemische Gebiete zu verhindern und das Risiko von Krankheitsausbrüchen zu verringern.
Zusammenfassung
Buschgelbfieber, auch bekannt als Dschungelgelbfieber oder Sylvatisches Gelbfieber, ist ein Subtyp des Gelbfiebers, der zwischen Stechmücken und wilden Primaten in bewaldeten Gebieten und gelegentlich auch durch Mückenstiche auf den Menschen übertragen wird. Es äußert sich durch Symptome wie Fieber, Kopfschmerzen, Muskelschmerzen, Übelkeit, Erbrechen und Gelbsucht, wobei schwere Fälle zu Multiorganversagen und Tod führen können. Diese Krankheit tritt vor allem in tropischen Regionen Afrikas und Südamerikas auf. Die Diagnose basiert auf der Beurteilung der Symptome und auf Labortests, wobei sich die Behandlung auf unterstützende Maßnahmen konzentriert, da es keine spezifischen antiviralen Behandlungen gibt. Zur Vorbeugung gehören die Impfung, die eine lang anhaltende Immunität bietet, und die Minimierung der Exposition gegenüber Moskitos durch Schutzmaßnahmen und Vektorkontrolle. Um einer Infektion vorzubeugen, sollten Sie sich vor Reisen in endemische Regionen impfen lassen und konsequent Mückenschutzmittel und andere persönliche Schutzmaßnahmen verwenden.